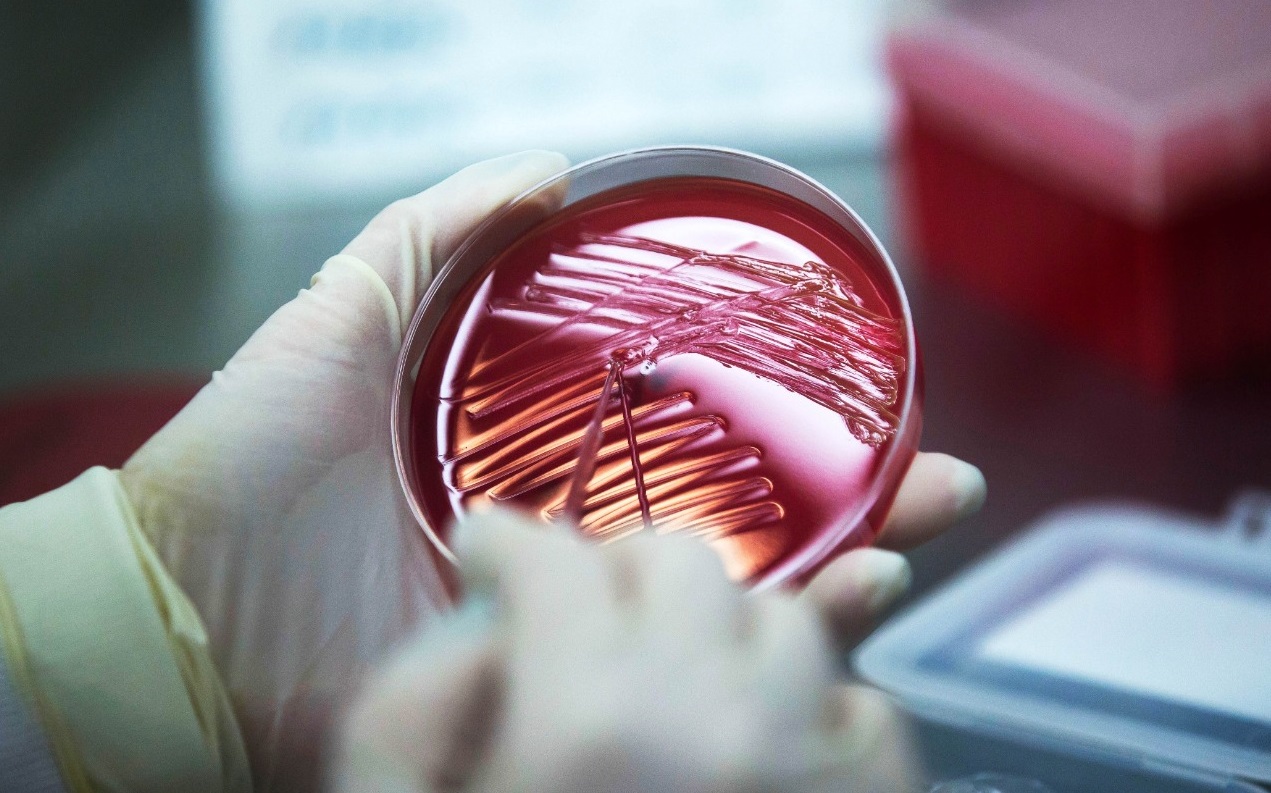

El director general de la Organización Mundial de la Salud (OMS), Tedros Adhanom Ghebreyesus, pidió el martes una nueva investigación sobre la hipótesis de un escape del virus del covid-19 de un laboratorio en China y criticó la falta de acceso de los expertos a los datos.
Aunque los científicos, que investigaron en enero y febrero en China el origen del virus, estimaron que esta posibilidad era la menos probable "esto requiere más investigación, probablemente con nuevas misiones con expertos especialistas, lo que estoy dispuesto a desplegar", aseguró el responsable.
En la presentación oficial del informe conjunto de los expertos de la OMS y científicos chinos sobre el origen del virus, el jefe de la institución dijo que la investigación permitió avanzar en el conocimiento "de forma importante", pero que había generado "otras cuestiones que necesitan otros estudios".
El informe, al que la Afp tuvo acceso el lunes, consideraba que era "extremadamente improbable" que el coronavirus se deba a un accidente o un escape de patógenos desde un laboratorio.
Pero este martes el doctor Tedros pidió una investigación más profunda de esta hipótesis con "expertos especialistas".
El jefe de la OMS también puso de manifiesto que el equipo internacional de expertos señaló que había tenido "dificultades" para "acceder a los datos originales" mientras estuvo en China.
"Espero que nuevos estudios colaborativos estarán basados en compartir los datos de una forma más amplia y rápida", agregó.
Edición: Ana Ordaz
El municipio contará con dos nosocomios renovados para brindar atención a las y los yucatecos
Astrid Sánchez
Alcaldesa Cecilia Patrón encabezó el festejo que fortalece el tejido social
La Jornada Maya
Reitera Rusia su apoyo a Cuba frente a situación ''verdaderamente difícil''
La Jornada
El reconocimiento del IMPI protegerá el patrimonio biocultural y fortalecerá la economía de comunidades mayas productoras
La Jornada Maya